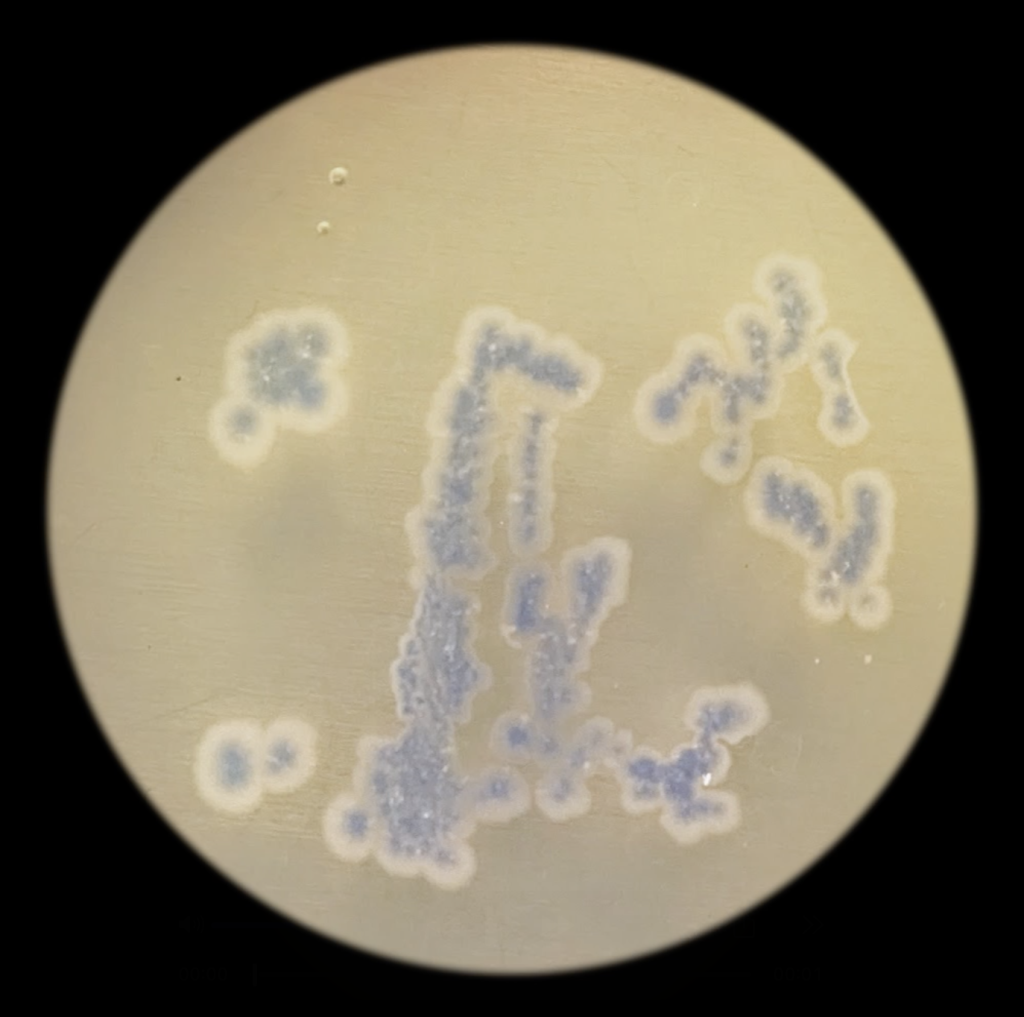
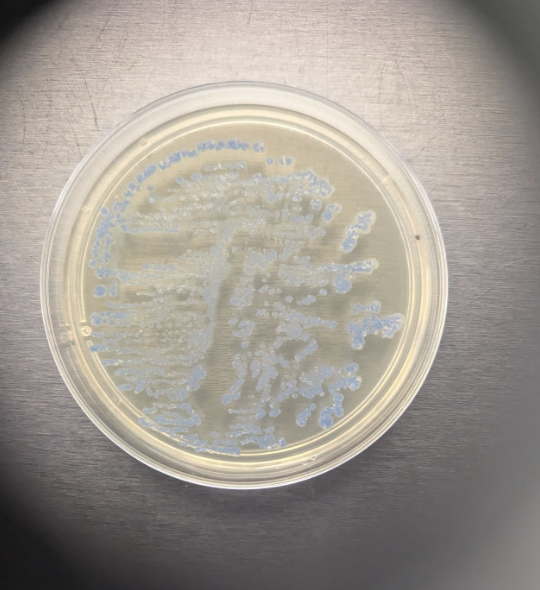

Megan Hillaker, Painting, 2026
Project Overview
The title of this piece, Psychopomp, refers to mythical characters that guide individuals through transitions. This project was inspired by a collaborative piece created earlier this year that explored themes of grief, change, and the passage between life and death through the mythical character of Mari Llwyd, a horse skull that appears during the new year and encompasses both celebration and mourning. I was interested in working collaboratively with the E. coli and creating a frame-by-frame animation that captured this quality of transcience and the cyclical nature of life and death.

Process
I began this process with the intention of using Kapton stencils to accurately represent the reference imagery. Although the first attempts at DNA modification did not turn out well and mostly produced white cells due to the backbone vectors connecting to themselves, after some color testing, I was more interested in the AE blue and the possibility that it might change color slightly with heat. The creation of the Kapton stencils also required some trial and error, and the resulting stencils were somewhat patchy and did not lie completely flat, but as I was working with the smaller plates, I did not believe this irregularity would be so much of an issue at the time.
I first created six test plates, spraying on the AE blue inoculated medium with a small mister, and peeling the stencils off after 24 hours for some and 48 hours for others. While the 24-hour plates did grow some colonies, the AE blue mostly did not express, except around the edge of the plate. The 48-hour plates seemed to have grown further, but were still completely obscured in areas, and the overall image was not readable. I then completed six more test plates in order to test spraying on the medium and immediately removing the stencil. These plates were checked at 24 hours and were a complete failure. I created alternative stencils with larger holes, but after checking on the remaining plates, I determined the stencils not to be cohesive with the progress of the project at this point.
I then created additional test plates, testing toothpicks and loupes, and drawing both the positive and negative of the reference frames. The AE blue expressed quite nicely and was much darker than any of the stencil plates. I believe that I was using too much media when spraying on the E. coli and not giving them enough space to grow properly.
With this information in mind, I then completed my six final plates, drawing on the image with a toothpick and checking them after 24 hours, at which point they had grown very well and were expressing the AE blue. After taking documentary photos, I stitched the images together in video editing software into the completed animation.